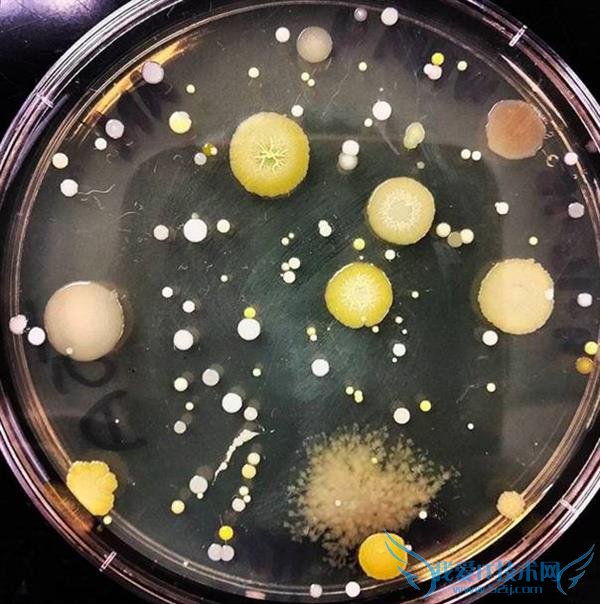
ƪ Ҳڲֻ

带手机去厕所已经成为我们大部分人的习惯了,没准儿你现在就在马桶上看这篇文章呢。
一边如厕,一边看手机,确实是个“双赢”行为,在工作或学习的间隙放松下头脑,还能解决自己的“大事”,何乐不为呢?
但要告诉你的是,上厕所的时候玩手机可能是你这辈子做过的最不健康的事了。
当然,这样说一定是要有根据的。美国亚利桑那大学的细菌学教授Charles Gerba和微生物学教授Kelly Reynolds近日就详细地告诉我们了卫生间内手机沾染上细菌的危险以及让你致病的可怕后果。

卫生间内细菌、微生物无处不在
Gerba教授说:“卫生间里微生物、病原体、肠道细菌非常多,这些脏东西大多来自人们的排泄物。”
这些专家认为,最容易让人感染到细菌的是厕所的门以及门把手和地板。
有研究表示,有四分之一的微生物都来自厕所地板上遗留的那些“排泄物”。
所以即使你洗过了你的手,你还是很有可能会接触水龙头、门把手等这些细菌感染的表面,然后让你再次感染。
至于每个厕所里这些微生物和细菌的量有多少,那就要看厕所的清洁力度了。
你自己的家由你自己控制,但是要是在公用厕所呢?后果你们自己好好想想吧。

被雾化的冲厕所水非常脏
Reynolds教授表示:“当你冲厕所的时候,这些沾染着大量细菌和尿液的水会在你看不见的情况下向每个方向飞出六尺高。”
这些“脏东西”含量会随着冲水次数而增加,所以如果是一个公共厕所,基本上可以肯定的是这些脏水已经污染了,更不用说你经常用来放手机的纸巾抽取的地方了。
Gerba教授表示要是这些纸巾是暴露在外面的,那真实的情况是怎样就更难说了。

这些细菌传播诺罗病毒、沙门氏菌让你致病
根据这些专家的说法,历史上曾有一段时间爆发过因诺罗病毒(引起急性肠胃炎的主要病因)、大肠杆菌、沙门氏菌(引起食物中毒)、志贺氏杆菌(引起腹泻)等引起的肠胃疾病,而这些病毒都是公共厕所的常客。
另外也要说一下,尿液并不是无菌的,它能够传播红眼病、呼吸道感染。
如果你的双手在厕所内解除到了这些细菌或微生物,然后又接触了你的脸、眼镜、鼻子、嘴巴,后果就比较严重了。
手机其实就是双手的延伸但它得不到清洁
当然,没有人会在上厕所的时候吃东西,但是你会不会在你把手机拿到厕所之后,开始吃东西的时候开始看手机呢?
这种情况很常见吧,当你的手接触了你的手机然后又接触了你的手机之后,很不幸,那些在厕所里沾染到的细菌又进入到了你的嘴里。
把手机带入厕所,就相当于你上完厕所之后没有洗手,这种说法一点都不夸张。
美国亚利桑那大学的调查显示,10部手机中有9部都有潜在可让人致病的微生物,其中16%的手机上含有排泄物的成分。
所以在洗手间里使用手机,其实就是把你的手机变成了一个移动细菌携带机,将这些细菌传染给自己或是别人。

手机还有掉进厕所的风险哦
除了让你的手机感染上细菌之外,当然还有一个风险就是不小心把你的手机掉到厕所里。
如果你最后把这部手机打捞上来了,那它可就完完全全沾上了上述的所有细菌,你还敢用这部手机吗?
最后别忘了,时常清洁自己的手机
如果你以前已经带你的手机去了厕所,别着急,用消毒液擦拭下是一个非常有效的方法。
不过Gerba教授也说了,这种措施只是适用于手机壳,更好的方法是用超细纤维或者是绒布,用稀释过的酒精从上到下前前后后清洁。
如果你的手机已经贴膜了,那这种方法就更容易了。

看完这篇文章,你以后还敢带手机去厕所吗?
- 评论列表(网友评论仅供网友表达个人看法,并不表明本站同意其观点或证实其描述)
-
